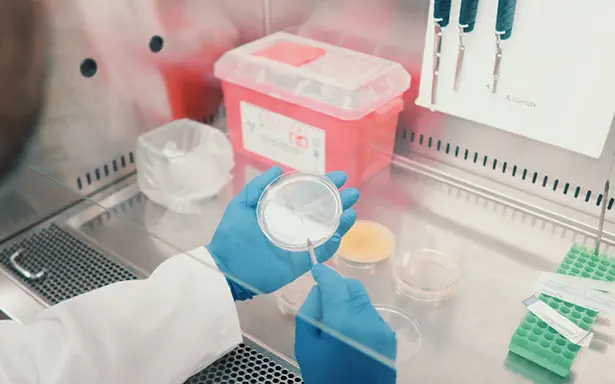

Biofiltración y Control de Gases Contaminantes: Diseñamos e implementamos sistemas de biofiltración basados en consorcios microbianos especializados para el control eficiente de olores y gases residuales, reduciendo emisiones atmosféricas y apoyando el cumplimiento de la normativa ambiental.
Nuestros
BIOFILTRACIÓN Y CONTROL
DESARROLLO
En Bioproc ofrecemos un servicio especializado de formulación y diseño de mezclas microbianas a la medida, basado en nuestro banco propio de microorganismos aislados y validados en condiciones reales de operación.
A través de análisis microbiológico, caracterización del residuo y pruebas controladas en laboratorio, desarrollamos consorcios específicos para cada proceso, optimizando la biodegradación de compuestos orgánicos e inorgánicos, la eficiencia del tratamiento, y la estabilidad operacional del sistema biotecnológico
ASESORÍA
Bioproc ofrece acompañamiento especializado en investigación, desarrollo e innovación (I+D+i) para empresas e instituciones académicas que buscan impulsar nuevas soluciones biotecnológicas. Nuestro equipo apoya desde la formulación y redacción de proyectos hasta la validación experimental, desarrollo de prototipos y pruebas piloto en contextos reales.
GESTIÓN
Te ayudamos a establecer un plan integral para el tratamiento y gestión de RILES, asegurando el cumplimiento de las normativas ambientales y la promoción de prácticas sostenibles.
SERVICIOS
Realizamos capacitaciones en temas ambientales y de emprendimiento para fomentar prácticas sostenibles y negocios responsables.